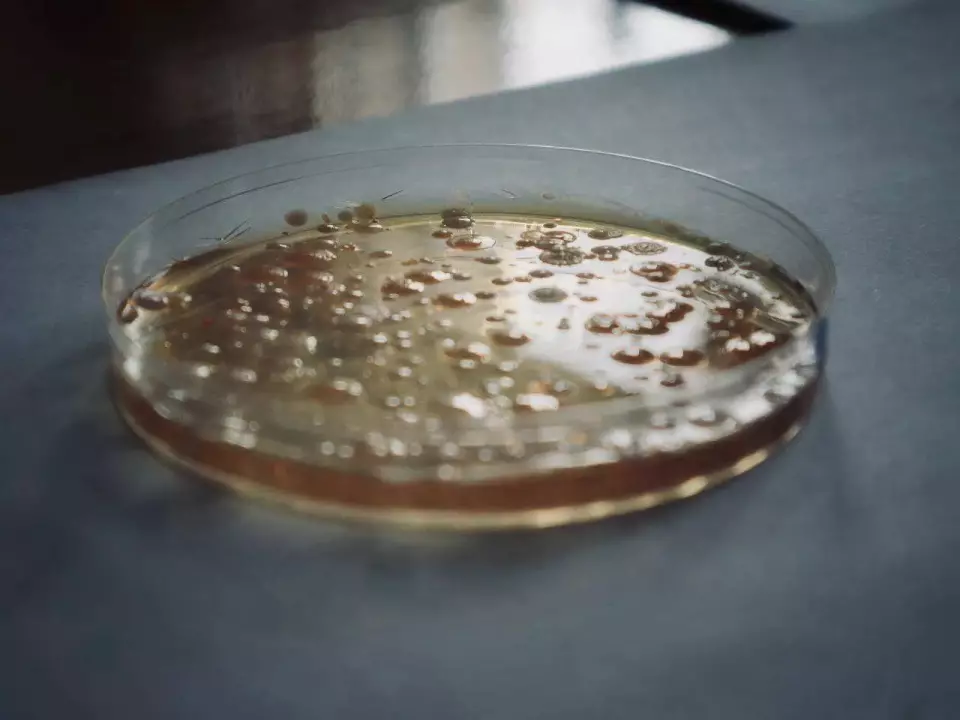
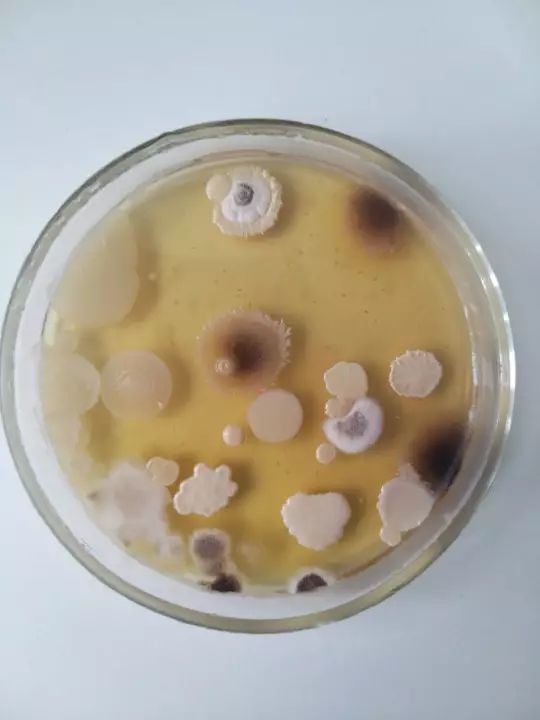
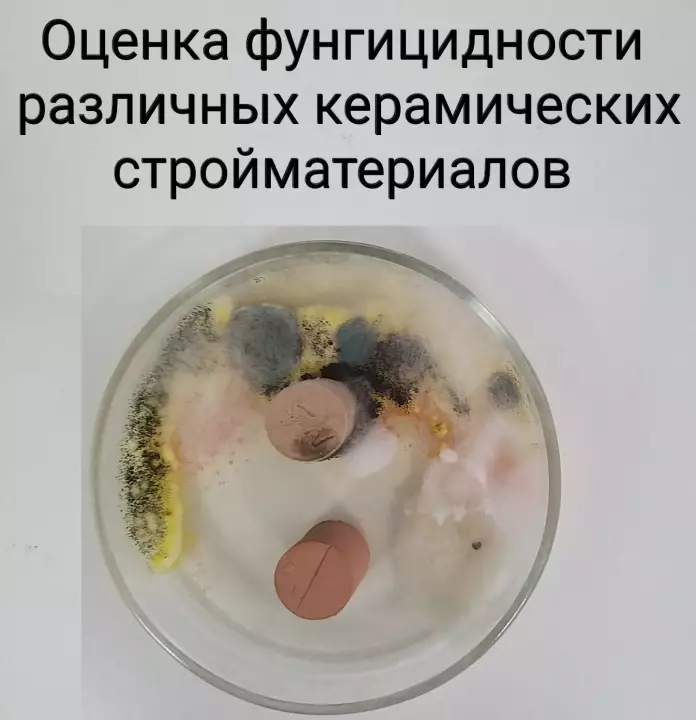
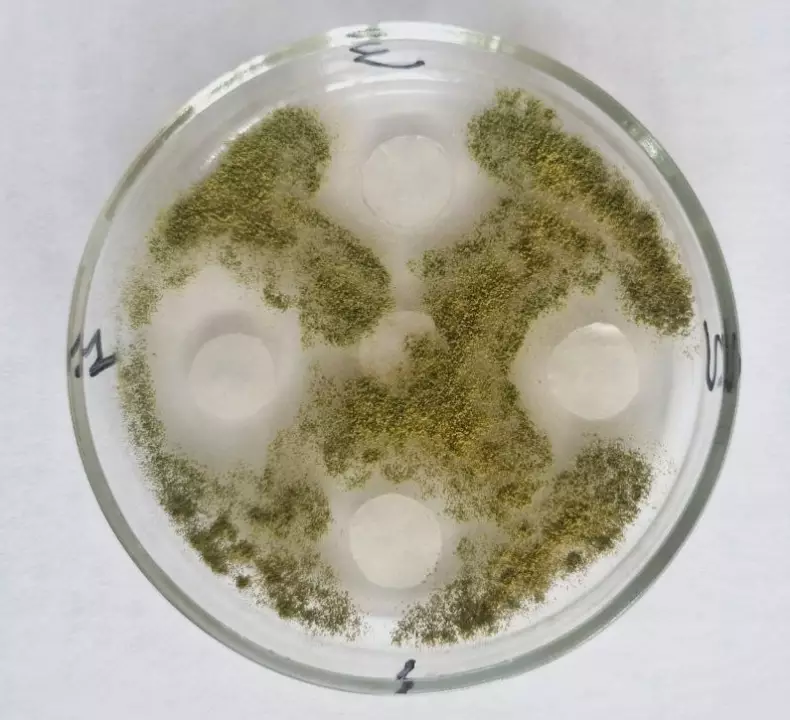

Научная деятельность
Научно-исследовательская деятельность студентов на кафедре
В процессе обучения на кафедре студенты исследуют строение и определяют размеры различных микроорганизмов под микроскопом, а также осуществляют их посев на жидкие и плотные питательные среды. Кроме того, на лабораторных работах проводят различные эксперименты по биологически активным веществам, входящим в состав живой клетки, осуществляют асептические мероприятия различных сред, изучают микробиоценозы поврежденных поверхностей и проверяют эффективность биоцидных препаратов, рекомендуемых для повышения биостойкости изделий.
Также студенты 4 курса направления 19.03.01 Биотехнология активно занимаются научной деятельностью в рамках дипломных работ в различных областях:
культивируют различные микроорганизмы и изучают их свойства для дальнейшего использования в промышленности и сельском хозяйстве;
разрабатывают новые питательные среды из отходов растениеводства;
исследуют биоповреждения различных строительных материалов и изделий, а также проводят санитарно-гигиенический анализ косметических средств, проверяя полученные результаты высевом различных микроорганизмов на плотные питательные среды;
проводят исследования по очистке модельных сточных вод и почв различными материалами, полученными из отходов промышленности и сельского хозяйства.
разрабатывают новые виды удобрений;
проводят токсикологическую оценку почв, загрязненных различными веществами;
осуществляют санитарно-гигиенический контроль очищенных сточных вод.
Научно-исследовательская деятельность кафедры
Основные направления научных исследований:
Исследование потенциала микробиоценозов для решения проблем ремедиации загрязненных почв.
Очистка сточных вод с использованием вторичных материальных ресурсов.
Разработка технологических решений получения белковых продуктов из отходов переработки масличных культур.
Изучение процессов биоповреждения различных материалов микроорганизмами и разработка способов их предотвращения.
Разработка технологических решений по переработке и использованию титансодержащих побочных продуктов доменного производства.
Снижение антропогенного воздействия на окружающую среду птице- и мясоперерабатывающего производства.
Оценка грибостойкости различных материалов и веществ
Патенты на изобретения и ноу-хау